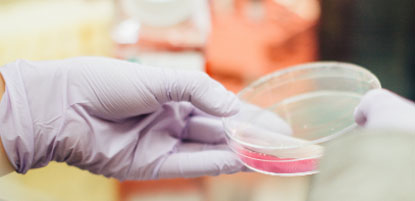

Estos son algunos de los campos donde nuestros consultores son expertos

Telco

Servicios financieros
- Banca
- Seguros
- Capital riesgo

Utilities

Productos y servicios de consumo
- Retail y distribución
- Programas de fidelización
- Packaging
Health
- Health
- Clínicas y hospitales
- Farma

Media
- Tv
- Internet
- Prensa
- Editorial

Construcción e inmobiliaria

Travel & Leisure
- Juego
- Travel
- Hospitality
- Restauración
- Leisure

Automoción y mobilidad
- Leasing / Renting
- Fabricantes
- Movilidad
- Vehículos eléctricos
- Car Sharing

Sector público
- Empresas públicas
- Smart cities
- Citizen analytics
